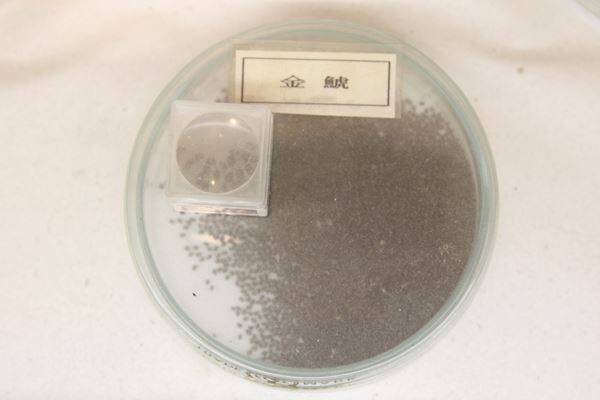

七夕の願い事は星にするものだが、伊豆シャボテン公園では、恋愛に関する願い事はサボテンにすることを提唱している。「なんて唐突なんだ」と思うところだが、実はサボテンの花言葉は「枯れない愛」。
おりしゃぼ(左)と、ひこしゃぼ(右)
シャボテン公園には「七夕縁結び企画」として、サボテンの「おりしゃぼ」と「ひこしゃぼ」が登場。2つのサボテン(竜神木:りゅうじんぼく)が赤い糸で結ばれており、願い事を書いた黄色の短冊をくくりつけて、愛の天の川をつくるというもの。
※ちなみに、「おりしゃぼ」「ひこしゃぼ」は、普段は「しゃぼこ」「しゃぼお」として鎮座している。
発案したのは、伊豆シャボテン公園植物エンターテイメント係の藤原里菜さん。藤原さんは大学で造園を中心に学んでいたが、サボテンの名前の面白さに気づいて以来、どっぷりとサボテンにハマってしまったという。念願叶って伊豆シャボテン公園で働くようになり、1500種のサボテン(多肉植物含)に囲まれる日々を送っている。しかも、家に帰ると、自分で買い集めた160種を超えるサボテン(多肉植物含)がお出迎えしてくれるという。
●サボテンは本当に枯れないの?
――サボテンは枯れないというイメージがありますが、水を与えなくても育つんですか?
「そのように思われがちですが、水を全く与えないと枯れてしまいます。ただ、あげすぎも厳禁でメリハリをつけて与えることが大事なんです」
必要な水分の量は、サボテンの大きさとも関係があるとのこと。
「枯れてしまいやすいのは、小さなサボテンの方なんです」
もともと、大きなサボテンは小さなサボテンよりも水分を多く含んでいるので、枯れる可能性は小さなものよりは低いとのこと。小さなサボテンを部屋に飾っている人は多いが、水を与えなくても大丈夫だと思って全くやらずに放置し続けていると、水分が蒸発して枯れることがあるので要注意。
「サボテン初心者の方は、小さなものよりは、にぎりこぶしくらいの大きさはあるようなサボテンを選んだほうが良いかもしれません」
●ここまで大きくなるサボテンも
ちなみに、「サボテンの王様」とも呼ばれている「金鯱(キンシャチ)」(サボテン科 エキノカクタス属)は、枯れずに育つとこのような感じで大きくなっていく。
(左から)40年モノ、20年モノ、50年モノ
さらに160年(推定)モノとなると……
高さ 118cm
周囲 270cm
重さ 250kg
「金鯱」は大型の玉サボテンで、開花まで30~50年もかかる。人間、25歳を超えるとお肌の曲がり角なんていう人がいるが、この話を聞くとなんだか希望が湧いてくるではないか。
ちなみに、種は1ミリ程度。(あまりにも小さいので、見づらくてすみません)
こんなに小さかったものが、あんなにデカくなるなんて。
縁起物ということで、「アナタもお一つ、お部屋にいかがだろう」と言いたいところだが、さすがにこんなにデカいと置けない。そこで、家にあると楽しくなりそうなサボテン(多肉植物含)を紹介。
●リプサリス
一見、サボテンに見えないが、サボテンの仲間である。原産地はブラジル。
茎は細長く、円柱状にからみ合っており、クリーム色の小さい花を咲かせる
「今、女性に人気のサボテンで、雑誌でも多く紹介されているので、部屋で育てている人が増えています」(藤原さん)
●入鹿(いるか)
地に横たわるように生長していくサボテンで、メキシコとカリフォルニアで自生。
見た目が変わっていて名前も可愛いので、遊びに来た友達に「これ、“いるか”っていうんだ~」と紹介したくなる。
先が生長すると、後ろのほうは枯れてなくなってしまう。
――では、なぜ「いるか」という可愛らしい和名がつけられたんですか?
「蘇我入鹿の首が切られた後も床を這いまわったという伝説からだそうです」
―― …………。
さきほど、「遊びに来た友達に『これ、入鹿っていうんだ~』と紹介したくなる」と書いたが、名前の由来までは紹介しないほうが良さそうだ。
●アルオウディア・アスケンデンス※多肉植物
マダガスカル島だけで見られるマダガスカルの固有の植物。
よく見ると、葉がハートの形をしている。冬になると落葉してしまうそうなので、今のうちに見ておきたいところ。
ところで……
いろいろなサボテンを見てきて、こんなことを思った人はいないだろうか?
「なんだか、おいしそう」
サボテンの仲間ではないが、見た目がサボテンっぽく見える多肉植物のアロエを思い出すと、料理にすると美味しいのではないかと思えてくる。
「ぜひ、サボテンを食べてみてください。おすすめですよ。おすすめ!」(藤原さん)
断る理由が一つも見当たらないので、伊豆シャボテン公園で食べられるサボテン料理を食べてみた。
▲サボテングリーンカレー ※サラダ付 (920円)
見た目以上にマイルドで食べやすい。肉はメキシカンポークを使用。
▲串焼き。「ねぎま」ならぬ「サボマ」(1本200円)。サボテンのコリコリ感がたまらない。
※こちらはカピバラ展示場前などで限定販売
▲サボテンアイス(290円)
※甘くて美味しいのに、後味が非常に爽やか。
(サボテンを使用したメニューは七夕以降も提供)
※使用されている食用サボテンは、輸入したものでは鮮度が落ちてしまうこともあり、種から育てる実生栽培日本一の愛知県春日井市で栽培された食用サボテン。
ちなみに、食用サボテンは、糖尿病・高コレステロール・動脈硬化・整腸作用・疲労回復・精神安定などに効果があるといわれている。また、名城大学 農学部の小原章裕教授の分析によると、春日井サボテンにはメラニンの蓄積を抑制することに起因する美白効果や発ガン物質を消去する力もあるので、ガンの予防効果についても期待されているという。
なるほど。私がサボテン料理をものすごく勧められたのもわかる気がする。確かに顔に疲労感があるし、肌の衰えも(以下略)。サボテンを使った料理も食べたことだし、良い人が現れますように。皆さんもサボテンに願いを。
(取材・文/やきそばかおる)
・伊豆シャボテン公園
JR伊東駅から東海バスでおよそ40分。7月19日(土)にはカピバラに触ることができる新施設「カピバラ虹の広場」がオープン。ワークショップ、カピバラのエサあげ体験やハンズオンなどさまざまな体験も。※「七夕縁結び企画」は7日まで。
ある意味、理にかなっているのである。

おりしゃぼ(左)と、ひこしゃぼ(右)
シャボテン公園には「七夕縁結び企画」として、サボテンの「おりしゃぼ」と「ひこしゃぼ」が登場。2つのサボテン(竜神木:りゅうじんぼく)が赤い糸で結ばれており、願い事を書いた黄色の短冊をくくりつけて、愛の天の川をつくるというもの。
※ちなみに、「おりしゃぼ」「ひこしゃぼ」は、普段は「しゃぼこ」「しゃぼお」として鎮座している。
発案したのは、伊豆シャボテン公園植物エンターテイメント係の藤原里菜さん。藤原さんは大学で造園を中心に学んでいたが、サボテンの名前の面白さに気づいて以来、どっぷりとサボテンにハマってしまったという。念願叶って伊豆シャボテン公園で働くようになり、1500種のサボテン(多肉植物含)に囲まれる日々を送っている。しかも、家に帰ると、自分で買い集めた160種を超えるサボテン(多肉植物含)がお出迎えしてくれるという。
●サボテンは本当に枯れないの?
――サボテンは枯れないというイメージがありますが、水を与えなくても育つんですか?
「そのように思われがちですが、水を全く与えないと枯れてしまいます。ただ、あげすぎも厳禁でメリハリをつけて与えることが大事なんです」
必要な水分の量は、サボテンの大きさとも関係があるとのこと。
「枯れてしまいやすいのは、小さなサボテンの方なんです」
もともと、大きなサボテンは小さなサボテンよりも水分を多く含んでいるので、枯れる可能性は小さなものよりは低いとのこと。小さなサボテンを部屋に飾っている人は多いが、水を与えなくても大丈夫だと思って全くやらずに放置し続けていると、水分が蒸発して枯れることがあるので要注意。
「サボテン初心者の方は、小さなものよりは、にぎりこぶしくらいの大きさはあるようなサボテンを選んだほうが良いかもしれません」
●ここまで大きくなるサボテンも
ちなみに、「サボテンの王様」とも呼ばれている「金鯱(キンシャチ)」(サボテン科 エキノカクタス属)は、枯れずに育つとこのような感じで大きくなっていく。

(左から)40年モノ、20年モノ、50年モノ
さらに160年(推定)モノとなると……

高さ 118cm
周囲 270cm
重さ 250kg
「金鯱」は大型の玉サボテンで、開花まで30~50年もかかる。人間、25歳を超えるとお肌の曲がり角なんていう人がいるが、この話を聞くとなんだか希望が湧いてくるではないか。
ちなみに、種は1ミリ程度。(あまりにも小さいので、見づらくてすみません)
こんなに小さかったものが、あんなにデカくなるなんて。
縁起物ということで、「アナタもお一つ、お部屋にいかがだろう」と言いたいところだが、さすがにこんなにデカいと置けない。そこで、家にあると楽しくなりそうなサボテン(多肉植物含)を紹介。
●リプサリス

一見、サボテンに見えないが、サボテンの仲間である。原産地はブラジル。
茎は細長く、円柱状にからみ合っており、クリーム色の小さい花を咲かせる
「今、女性に人気のサボテンで、雑誌でも多く紹介されているので、部屋で育てている人が増えています」(藤原さん)
●入鹿(いるか)

地に横たわるように生長していくサボテンで、メキシコとカリフォルニアで自生。
見た目が変わっていて名前も可愛いので、遊びに来た友達に「これ、“いるか”っていうんだ~」と紹介したくなる。
先が生長すると、後ろのほうは枯れてなくなってしまう。
まるで這うように前進しているように見えるため、現地では「地を這う悪魔」と呼ばれている。
――では、なぜ「いるか」という可愛らしい和名がつけられたんですか?
「蘇我入鹿の首が切られた後も床を這いまわったという伝説からだそうです」
―― …………。
さきほど、「遊びに来た友達に『これ、入鹿っていうんだ~』と紹介したくなる」と書いたが、名前の由来までは紹介しないほうが良さそうだ。
●アルオウディア・アスケンデンス※多肉植物

マダガスカル島だけで見られるマダガスカルの固有の植物。
よく見ると、葉がハートの形をしている。冬になると落葉してしまうそうなので、今のうちに見ておきたいところ。
ところで……
いろいろなサボテンを見てきて、こんなことを思った人はいないだろうか?
「なんだか、おいしそう」
サボテンの仲間ではないが、見た目がサボテンっぽく見える多肉植物のアロエを思い出すと、料理にすると美味しいのではないかと思えてくる。
「ぜひ、サボテンを食べてみてください。おすすめですよ。おすすめ!」(藤原さん)
断る理由が一つも見当たらないので、伊豆シャボテン公園で食べられるサボテン料理を食べてみた。

▲サボテングリーンカレー ※サラダ付 (920円)
見た目以上にマイルドで食べやすい。肉はメキシカンポークを使用。

▲串焼き。「ねぎま」ならぬ「サボマ」(1本200円)。サボテンのコリコリ感がたまらない。
※こちらはカピバラ展示場前などで限定販売

▲サボテンアイス(290円)
※甘くて美味しいのに、後味が非常に爽やか。
(サボテンを使用したメニューは七夕以降も提供)
※使用されている食用サボテンは、輸入したものでは鮮度が落ちてしまうこともあり、種から育てる実生栽培日本一の愛知県春日井市で栽培された食用サボテン。
ちなみに、食用サボテンは、糖尿病・高コレステロール・動脈硬化・整腸作用・疲労回復・精神安定などに効果があるといわれている。また、名城大学 農学部の小原章裕教授の分析によると、春日井サボテンにはメラニンの蓄積を抑制することに起因する美白効果や発ガン物質を消去する力もあるので、ガンの予防効果についても期待されているという。
なるほど。私がサボテン料理をものすごく勧められたのもわかる気がする。確かに顔に疲労感があるし、肌の衰えも(以下略)。サボテンを使った料理も食べたことだし、良い人が現れますように。皆さんもサボテンに願いを。
(取材・文/やきそばかおる)
・伊豆シャボテン公園
JR伊東駅から東海バスでおよそ40分。7月19日(土)にはカピバラに触ることができる新施設「カピバラ虹の広場」がオープン。ワークショップ、カピバラのエサあげ体験やハンズオンなどさまざまな体験も。※「七夕縁結び企画」は7日まで。
編集部おすすめ